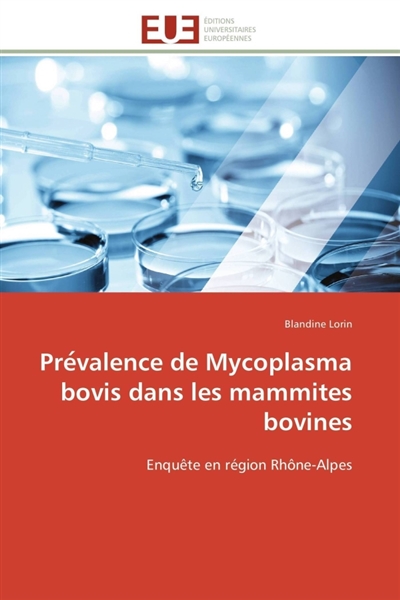
Pre valence de mycoplasma...

Frais de port offerts : dès 19€ en Locker Mondial Relay et 29€ en Colissimo (France Métropolitaine)
Neuf
21,50 €
- Nouveau